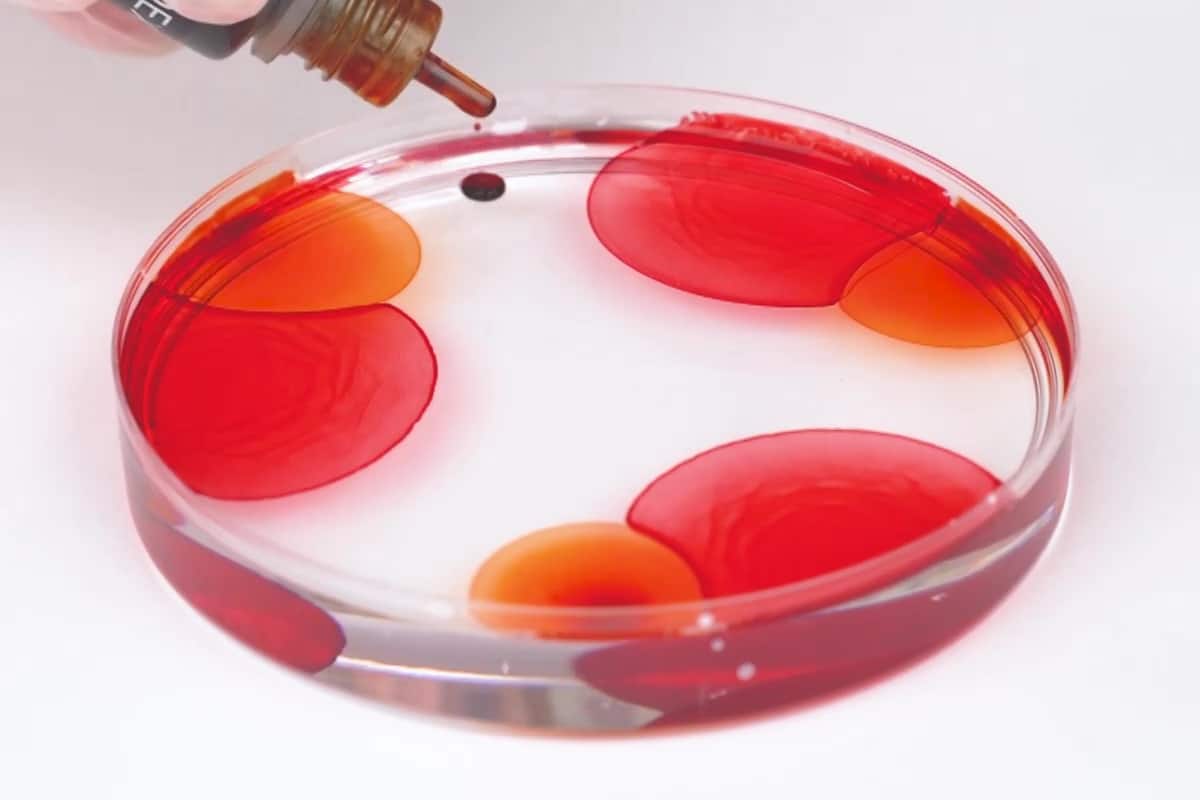
alcohol-ink-epoxy-petri-art

Alcohol Ink for Epoxy Resins
Alcohol Ink for Epoxy Resins
Coloring agent for Alcohol ink effects
Delivery time: 1-3 business days | Free shipping on orders over $50
The EPODEX Alcohol Inks are highly concentrated alcohol inks for the realization of color effects. Depending on the selection, one or more 10g(1/3fl.oz) bottles are included in the delivery. For the typical Alcohol Ink effect, you can optionally order white dye. The more white dye used, the stronger the effect.
Highly concentrated Due to our high pigmented formula, you will only need a small amount to achieve the best results.
Select your color
Color Selection
-
Starting at $29.99
-
Starting at $3.99
-
Starting at $3.99
-
Starting at $3.99
-
Starting at $3.99
-
Starting at $3.99
-
Starting at $3.99
-
Starting at $3.99
-
Starting at $3.99
-
Starting at $3.99
-
Starting at $3.99
-
Starting at $3.99
-
Starting at $3.99
-
Starting at $3.99
-
Starting at $3.99
-
Starting at $18.99
-
Starting at $9.99
-
Starting at $16.99
-
Starting at $9.99
-
Starting at $16.99
SKU: CL-ALK
Category: Pigments & Colorants